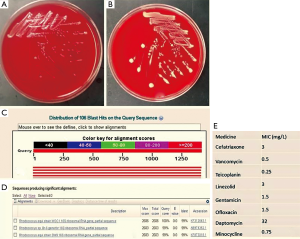

Rare and persistent Rhodococcus equi infection in a diffuse large B cell lymphoma patient: case report and review of the literature
Introduction
Rhodococcus equi (R. equi) formerly corynebacterium equi (C. equi), is an uncommon gram positive organism. It has been collected from soil, water, horses, cattle, swines and wild birds. R. equi is a rare but recognized pathogen in humans and has emerged as an important cause of morbidity and mortality among immunocompromised patients. It need combined treatment with effective antibiotics, and often requires the immune adjuvant therapy, due to survival inside histiocytes, immunocompromised, the site(s) and extent of infection, the duration of treatment is uncertain. A minimum of 6 months of antibiotic therapy is typically required for immunocompromised patients. Here we reported a 49-year-old man presented dyspnea with fever, skin ulcer for 5 months and the final diagnosis was diffuse large B cell lymphoma with R. equi septicemia and pneumonia, the treatment was failure, the blood culture was always positive during the course of disease, though he was given combined treatment with effective antibiotics. Perhaps the immune reconstitution or immune supportive treatment is more important.
Case report
In this article, the patient’s history was divided into four parts to describe according to the treatment course and the change of disease.
The local hospital—February
A 49-year-old man presented dyspnea with fever, skin ulcer for 5 months. He had hewed out the stones for 8 years and then operated “meat pie shop” to now more than 10 years, denying that smoking and the history of tuberculosis. About 5 months ago, he had a temperature of almost 39 degrees, accompanied by shortness of breath, left cape side skin itching (a thumb nail sized red lesions with 4-5 gibbous red papules, no damage, and purulent), no cough and expectoration. White blood cell, neutrophils were normal, but lymphocytes decreased significantly: 0.2-0.7 (1.1×109-3.2×109/L), T-SPOT.TB and cryptococcal latex agglutination test, LDH were negative. Left lip pathology: ulcer with hyperplasia of squamous epithelium. Lung CT (Figure 1): multiple lesions in both sides with left lower lobe mass, cancer with two multiple pulmonary metastases may be; two pulmonary diffuse military and small nodules. Pathology of the left lower mass (the local hospital): suppurative granulomatous inflammation; pathology consultation of The First Hospital of Zhejiang Province: suppurative granulomatous inflammation, morphology of fungal infection was first considered. Twice-positive blood cultures were corynebacterium jeikeium: sensitive to vancomycin, imipenem, cefepime, ciprofloxacin, SMZ-TMP, cefotaxime, linezolid, and erythromycin. The patient’s condition did not improve after two weeks’ treatment of vancomycin, levofloxacin and voriconazole, and review the lung CT (Figure 1B): lung lesions progress than before.

The First Affiliated Hospital of Zhejiang University—March-May
Then to The First Hospital of Zhejiang Province for further diagnosis. Pathology of bronchoscopy (Figure 2): (lower left dorsal segment) mucosa of chronic inflammation with granuloma formation. Bone marrow routine: granulocyte increased active. It did not improve after two weeks’ empirical anti-infective therapy of moxifloxacin and voriconazole. After that, many times of culture were R. equi: blood culture (twice), bone marrow culture (once), sputum culture (once), sensitive to ceftriaxone, vancomycin, moxifloxacin, clindamycin, and erythromycin. He was then treated with moxifloxacin and vancomycin, the patient’s condition improved after 5 days’ treatment: no fever; breath better; but left lip skin ulcer did not improve, and after 43 days’ treatment, lung CT (Figure 1C): better than before. However, blood cultures remained positive during the treatment: after 2 weeks and 43 days respectively.

The local hospital—June
They disable all medication because he appeared serious systemic rash after 43 days’ therapy of “moxifloxacin and vancomycin”. Rash slightly, but symptoms of fever and dyspnea began from 1 week after discontinuance, and he got a new ulcer in the right alar (2 cm in diameter). Hence to treated with moxifloxacin, rifampicin and SMZ-TMP. Symptoms ibid, rash worsened, so removed all drugs, then gave methylprednisolone and immunoglobulin for 3 days, sequential oral methylprednisolone and loratadine for 10 days, rash subsided, lung CT (Figure 1D) improved, but still have a fever, shortness of breath with skin ulcer (Figure 2A,B), blood culture was also R. equi. Then treated with caspofungin 3 days, moxifloxacin and rifampicin 3 days, sulperazone 2 days, but symptoms ibid, and review the lung CT (Figure 1E): pulmonary lesions progress.
Sir Run Run Shaw Hospital (SRRSH)—July
Department of respiration: lung CT (Figure 1F) showed pulmonary lesions progress obviously: the left lower pulmonary mass, tumor? The fuzzy patch scattered in both sides of the lung. Pathology of the left corner of the mouth (Figure 2C): chronic inflammation with necrosis of skin, with virus infection. Treated with moxifloxacin and teicoplanin for 2 days; cefoperazone sulbactam, ciprofloxacin and fluconazole for 4 days, levofloxacin combined with methylprednisolone for 10 days, because the patient’s condition did not improve, and the family refused to continue the current treatment, so to department of infectious disease for further treatment. Combined with the local data, we can’t exclude that histoplasmosis infection and R. equi infection, but had no malignant basis at least. He was given 10 days treatment with amphotericin B, imipenem, linezolid, methylprednisolone, and lung biopsy again. However, in the 10 days’ treatment of our department, patients with progressive dyspnea and fever, lung CT (Figure 1G) and X-ray (Figure 1H) showed pulmonary diffuse lesions progress obviously and finally died of respiratory failure. To our surprised, the final pathology result was diffuse large B cell lymphoma (Figure 2D), the last 3 times blood cultures were all positive, and the isolate was identified as corynebacterium by BioMérieux Vitek2 (Figure 3A,B), 16S RNA sequencing was further performed and finally confirmed the isolate was R. equi (Figure 3C,D). We borrow patient’s pathology slices outside the hospital, the full field of vision were plenty of gram positive cocci (Figure 2E), but were not described by the front two hospitals. The summary of main clinical, laboratory and imaging findings from patient was shown in Tables 1,2.

Full table

Full table
Discussion
R. equi, formerly C. equi, is an uncommon gram positive organism belonging to the group of mycolata (mycolic acid containing bacteria), that also incorporates the genera nocardia, corynebacterium and so on, it’s hard to treat mostly owing to the establishment of intracellular niches (1,2). Colonies form on solid media appears irregularly round, smooth, semitransparent, glistening and mucoid (3) after incubation for 24 and 48 hours respectively (Figure 3A,B). R. equi has been collected from soil, water, horses, cattle, swines and wild birds, and concentrations are high in horse feces (1,2). However, the transmission of R. equi is not entirely clear; the patient of this case had no history of exposure to livestock obvious. It can cause dangerous opportunistic infections.
R. equi was first reported in 1923 in foals with pyogranulomatous pneumonia (4), with the first human infection being diagnosed in 1967 (5). The vast majority of patients infected with R. equi are immunocompromised, and more than 60% have human immunodeficiency virus infection (1,6,7), some have transplant recipient (8,9), only a few suffering from lymphoma, and most of them are Hodgkin’s lymphoma, there are no reports of R. equi infection in diffuse large B cell lymphoma patients. Unlike the case, they were all secondary infection after chemotherapy in many of these lymphoma patients, most can be cured after treated by antibiotic plus chemotherapy, immune supportive treatment such as IVIG.
Clinical manifestation of R. equi infection are protean, includes fever, chills, nonproductive cough, dyspnea, weight loss, hemoptysis, and pleuritic pain etc. (3,8,10), although pulmonary infection is present up to 80% and bacteremia occurs in >80% cases (11). May be associated with invasion of the mononuclear phagocyte system, perhaps the ability of continued destruction of alveolar macrophages is the foundation of its pathogenicity, often accompanied by granuloma formation (1,11,12), caused sub-acute pneumonia with cavity and bacteremia. The mortality rate as high as 60% in immunocompromised people, infection serious degree and scavenging ability were closely associated with CD4 lymphocyte count, that is, you can improve the therapeutic effect by inducing immune reconstitution (2,6,11,13). Combination antibiotic therapy is the mainstay of treatment; R. equi is usually susceptible to erythromycin, rifampin, fluoroquinolones, aminoglycosides, glycopeptides and imipenem. Susceptibility to cotrimoxazole, tetracycline and clindamycin is variable (1,2,11), some studies such as tygecycline, vancomycin and linezolid have also successfully been used in patients (2,14-16). Like most have reported cases, due to survival inside histiocytes, immunocompromised, the site(s) and extent of infection, diseases are commonly chronic and recurrent (2), and the duration of treatment is uncertain. A minimum of 6 months of antibiotic therapy is typically required for immunocompromised patients with pulmonary, bone or multi-system infection (1,2,11,13,17).
In our study, the patients had been successively applied vancomycin, rifampin, moxifloxacin, cotrimoxazole, and when to our department, we give patient with linezolid, vancomycin, imipenem, levofloxacin, but there still were positive blood cultures during and after the whole combined treatment. The total T lymphocyte and T helper/inducer cell of the patients were very low at the onset of the first, but improved obviously after the application of methylprednisolone and immunoglobulin because of rashes, and at the same time we also found the pulmonary lesions improved than before, perhaps the immune reconstitution or immune supportive treatment more important. On the other hand, if we noticed a change of these, and further to look for the underlying diseases more actively, then given the long-term immune supportive treatment or chemotherapy, perhaps these aggressive treatment strategies can cure or significantly prolong the life of patient.
In addition, the patient of this case suffered from repeated puncture, however, we should know the positive rate of percutaneous lung biopsy is closely related with operator level of experience, distance of the lesion from the pleural surface, target lesion size, needle type, guide positioning map, pathology expert’s experience (18,19). I hope we should do what we can as far as possible to improve the positive rate of puncture, which can provide the basis for clinical diagnosis as early as possible, and increase the survival rate of the patients.
Conclusions
In areas of the world where laboratory facilities are lacking, and for immunocompromised patients, R. equi infection should be considered in the differential diagnosis of a “mycobacterium-like” illness with negative smear results. And R. equi should always be considered as a potential pathogen in any immunocompromised patient and especially with cavitary pneumonia (10), like the first reaction when saw pneumocystis carinii, we need to learn what causes the immune-suppression, and further studies and procedures are often required, including CT, BAL, and transbronchial or percutaneous biopsy.
In addition, when the treatment effect is not good in immunocompromised patients, we must clearly know the importance of an effective immune recovery. Most importantly, Isolation of any of rare pathogens in practice should require a thorough search for possible malignant diseases, for example, the association between group bovis bacteremia and colon carcinoma (20,21).
Because the experience of pathology and microbiology doctors is very different, incompetent physicians will cause a high rate of misdiagnosis. We would increase clinicians’ awareness of this pathogen’s morbidity in compromised people and to improve the likelihood of its accurate and timely diagnosis. Further clinical and laboratory research is needed to better define the routes of acquisition and the mechanisms of pathogenesis of R. equi infection and the appropriate treatments for it.
Acknowledgements
Disclosure: The authors declare no conflict of interest.
References
- Weinstock DM, Brown AE. Rhodococcus equi: an emerging pathogen. Clin Infect Dis 2002;34:1379-85. [PubMed]
- Savini V, Salutari P, Sborgia M, et al. Brief Tale of a Bacteraemia by Rhodococcus equi, With Concomitant Lung Mass: What Came First, the Chicken or The Egg? Mediterr J Hematol Infect Dis 2011;3:e2011006. [PubMed]
- Yamshchikov AV, Schuetz A, Lyon GM. Rhodococcus equi infection. Lancet Infect Dis 2010;10:350-9. [PubMed]
- Magnusson H. Spezifische infektiose pneumonie beim fohlen: ein neuer eitererreger beim pferd. Arch Wiss Prakt Tierheilkd 1923;50:22-38.
- Golub B, Falk G, Spink WW. Lung abscess due to Corynebacterium equi. Report of first human infection. Ann Intern Med 1967;66:1174-7. [PubMed]
- Ferretti F, Boschini A, Iabichino C, et al. Disseminated Rhodococcus equi infection in HIV infection despite highly active antiretroviral therapy. BMC Infect Dis 2011;11:343. [PubMed]
- Topino S, Galati V, Grilli E, et al. Rhodococcus equi infection in HIV-infected individuals: case reports and review of the literature. AIDS Patient Care STDS 2010;24:211-22. [PubMed]
- Hayes D Jr, Diaz-Guzman E, Hoopes CW. Rhodococcus equi infection after lung transplantation. Respir Care 2011;56:1605-7. [PubMed]
- Behnes CL, Neumann S, Schweyer S, et al. Pleural malakoplakia caused by Rhodococcus equi infection in a patient after stem cell transplantation. Diagn Pathol 2012;7:20. [PubMed]
- Gallant JE, Ko AH. Cavitary pulmonary lesions in patients infected with human immunodeficiency virus. Clin Infect Dis 1996;22:671-82. [PubMed]
- Torres-Tortosa M, Arrizabalaga J, Villanueva JL, et al. Prognosis and clinical evaluation of infection caused by Rhodococcus equi in HIV-infected patients: a multicenter study of 67 cases. Chest 2003;123:1970-6. [PubMed]
- Takai S, Sasaki Y, Ikeda T, et al. Virulence of Rhodococcus equi isolates from patients with and without AIDS. J Clin Microbiol 1994;32:457-60. [PubMed]
- Ng S, King CS, Hang J, et al. Severe cavitary pneumonia caused by a non-equi Rhodococcus species in an immunocompetent patient. Respir Care 2013;58:e47-50. [PubMed]
- Akilesh S, Cross S, Kimmelshue K, et al. Pseudotumor of the tracheal-laryngeal junction with unusual morphologic features caused by Rhodococcus equi infection. Head Neck Pathol 2011;5:395-400. [PubMed]
- El-Mofty SK, Akilesh S. Infectious pseudotumors: red herrings in head and neck pathology. Head Neck Pathol 2012;6:58-63. [PubMed]
- Russo G, Lichtner M, Carnevalini M, et al. Primary retroperitoneal abscesses due to Rhodococcus equi in a patient with severe nephrotic syndrome: successful antibiotic treatment with linezolid and tigecycline. Int J Infect Dis 2010;14:e533-5. [PubMed]
- Denes E, Peignon-Orsoni D, Terrade FX. Nonhealing wound due to Rhodococcus equi in an apparently immunocompetent patient, revealing CD8+ T-lymphocyte deficiency. J Clin Microbiol 2010;48:4658-60. [PubMed]
- Capalbo E, Peli M, Lovisatti M, et al. Trans-thoracic biopsy of lung lesions: FNAB or CNB? Our experience and review of the literature. Radiol Med 2014;119:572-94. [PubMed]
- Boskovic T, Stanic J, Pena-Karan S, et al. Pneumothorax after transthoracic needle biopsy of lung lesions under CT guidance. J Thorac Dis 2014;6:S99-107. [PubMed]
- Vollmer T, Hinse D, Kleesiek K, et al. Interactions between endocarditis-derived Streptococcus gallolyticus subsp. gallolyticus isolates and human endothelial cells. BMC Microbiology 2010;10:78. [PubMed]
- Boleij A, van Gelder MM, Swinkels DW, et al. Clinical Importance of Streptococcus gallolyticus infection among colorectal cancer patients: systematic review and meta-analysis. Clin Infect Dis 2011;53:870-8. [PubMed]